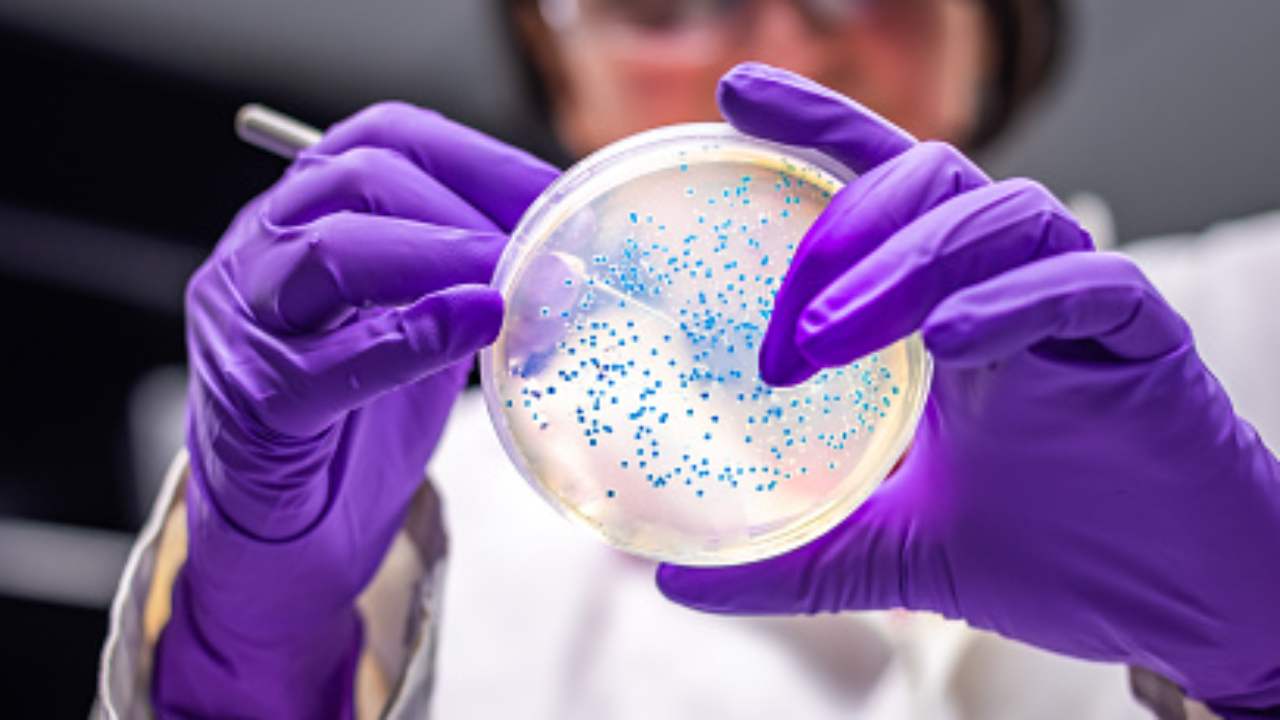

Richiamo alimentare di Tiger. Banana chips e muesli contaminate da salmonella. Non mangiare assolutamente

Continuano i richiami alimentari pubblicati su “Il fatto alimentare”. La rivista dall’inizio dell’anno ha segnalato 112 allerte su prodotti contaminati. Questa è la volta della catena Tiger. Due prodotti della multinazionale spagnola, sono sospetti di contaminazione da salmonella.
Nello specifico stiamo parlando dei Banana Chips e muesli. Il primo è venduto in confezione da 125 grammi. Il numero di lotto sospetto è 8008634 e la data di scadenza 16/09/2021.
Il secondo è il muesli mix, in confezione da 150 grammi con i numeri di lotto 8008911 e 8009035 e la data di scadenza 14/10/2021.
La multinazionale Flying Tiger Copenhagen avverte che l’allerta coinvolge molti paesi europei: Italia, Spagna, Francia, Belgio, Danimarca, Ungheria, Austria, Norvegia, Finlandia, Svezia, Paesi Bassi, Polonia, Estonia, Repubblica Ceca, Islanda, Slovacchia, Germania, Cipro, Grecia e Lituania.
Leggi anche: Raddoppia l’utilizzo di antibiotici negli allevamenti suini, la scoperta di alcuni giornalisti inglesi
Cos’è la contaminazione da salmonella
La salmonella è un batterio che raggiunge l’uomo per via oro-fecale. Le principali fonti d’infezione sono alimenti e acqua contaminata. Le conseguenze della salmonella possono avere differenti livelli di gravità. Si passa da dolori addominali, vomito e dissenteria e febbri tifoidee e compromissione epatica.
Generalmente è più facile essere infettati in seguito all’ingestione di prodotti crudi, specie se di origine animale, ma in altri casi, come quello qui esposto, le cause possono essere differenti.
I prodotti industriali, specie se conservati sottovuoto o in buste di plastica, sono facilmente soggetti a contaminazioni batteriche nel caso vi sia una scorretta gestione della temperatura o compromissione dell’integrità della confezione. A volte le cause della contaminazione sono riconducibili ad errori nella fase di produzione dell’alimento.
Leggi anche: Produrre soltanto plastica riciclata dal 2040, l’appello di un gruppo di studiosi su Science
Nel caso in cui si acquistassero i prodotti sopra indicati si consiglia di gettarli immediatamente o riconsegnarli al punto vendita.